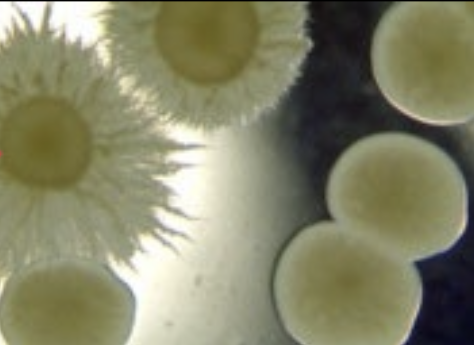
term image
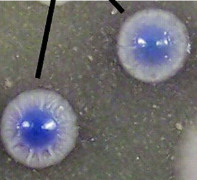
term image
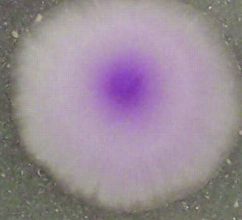
term image
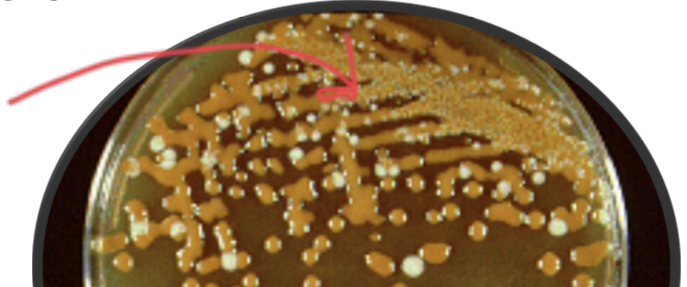
term image
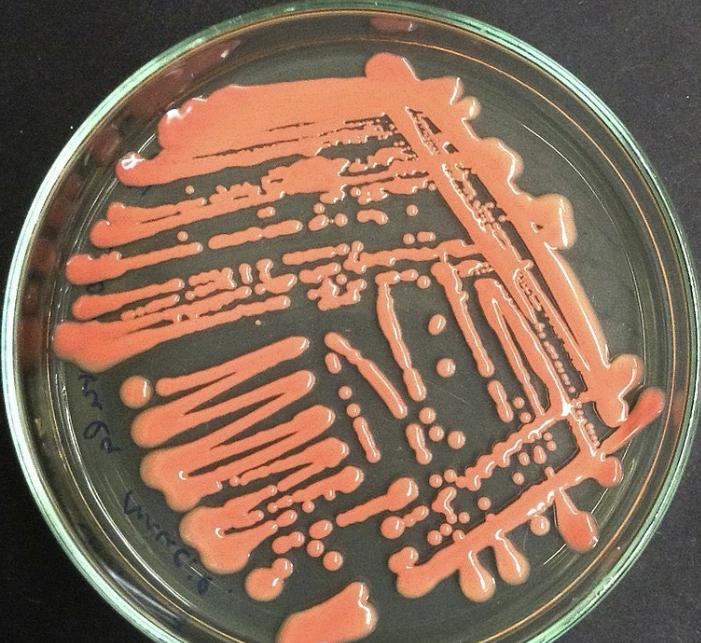
term image

1/21
Looks like no tags are added yet.
Name | Mastery | Learn | Test | Matching | Spaced | Call with Kai |
|---|
No study sessions yet.

Inflammatory candida causing pustules
Candida albicans footed colonies on BAP or SAB or BHI

Candida albicans form hyphae/pseudohyphae and chlamydospores on a Dalmau plate using agar (such as Cornmeal & Tween 80 agar)

Budding yeast

Pseudohypha

Blastoconidia

CHROMagar

C. albicans
C. tropicalis

C. glabrata

C. dubliniensis
C. krusei

Cryptococcus neoformans: India ink prep of characteristic capsule from a CSF specimen
C. neoformans on bird seed agar

Candida albicans on bird seed agar
Rhodotorula

S. cerevisiae

Pneumocystis

Pneumocystis cysts (silver stain)
L
Candida albicans on Sabouraud-Dextrose Agar
Candida albicans budding cells